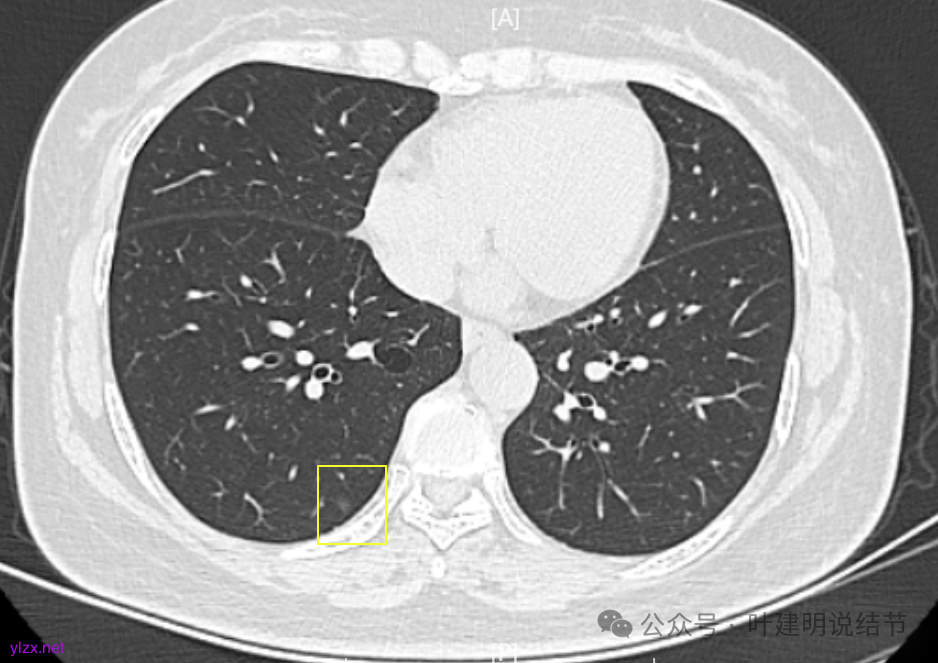
图片

问诊分析:三年前问诊我就建议她好手术了,她没开!三年过去了,现在如何了?
时间:2025-04-24 12:11:31 热度:37.1℃ 作者:网络
基本信息:
女性, 59岁(第一次问诊时的年纪)
第一次问诊:2022年11月
疾病描述:
1.2021年12月因感冒咳嗽做了胸部CT,显示多发结节。有大的0.7*0.5cm。
2.2022年5月2日复查增强CT,显示肺结节0.7*0.6cm
3.2022年5月10日某A医院MDT,建议穿刺。
4.2022年7月31日做了ct复查,报告显示结节增大,0.8*0.7cm。
5.去B医院胸外科面诊,医生建议可继续观察6个月。
目前患者对结节比较焦虑,也在寻求中药或去南方疗养。患者身体一直不是很好,自从发现结节后睡眠不是很好,且主述偶尔胸口疼,2022年9月短暂住院一周,做了全身检查,未发现异常。
希望得到的帮助:
1.判断结节的良恶性。2.下一步的诊疗建议,是要立即切除还可以继续观察?3.是楔切还是段切?
影像展示与分析:






病灶7:右下叶胸膜下淡而微小的磨玻璃结节,考虑肺泡上皮增生可能性大。
我的意见:
两肺多发结节,持续存在,总体上看,瘤肺边界清,轮廓清楚,主病灶有血管穿行,表面也不平,考虑微浸润性腺癌可能性大,其他2处不典型增生或原位癌可能性大些。总的来说,风险还不大,也不会引起胸痛症状,但因两侧都有,且可能后续均是要手术的,个人觉得左侧病灶可以考虑先切除,因为两个病灶离得不远,总的来说还是靠边缘的,定位后楔形切除能将两处都切了。这样只需再关注右侧的,以后真右侧也要手术,也可拉长两次手术的间隔时间,有利于恢复以及耐受性会好些。两侧同时手术,疼痛、咳嗽、恢复情况容易差些,也容易合并肺炎或其他并发症,安全性差一点的。以上意见供参考!
第二次问诊:2025年4月
疾病描述:
1.2021年12月因感冒咳嗽做了胸部CT,显示多发结节。有大的0.7*0.5cm。
2.2022年5月2日复查增强CT,显示肺结节0.7*0.6cm 3.2022年5月10日A医院MDT,建议穿刺。
4.2022年7月31日做了ct复查,报告显示结节增大,0.8*0.7cm。
5.2022年8月去A医院胸外科面诊,您建议可继续观察6个月。
6. 2022年9月短暂住院一周,做了全身检查,包括胃镜肠镜心电图24小时监测等,未发现异常。
7.2022年11月1日B医院复查ct,显示肺结节0.89*0.51cm。其余变化不大。
8.2023年1月B医院复查ct,显示最大肺结节0.85*0.73cm,其余变化不大。
9.2023年4月复查ct,显示最大肺结节0.79*0.72。2023年3月短暂去某地疗养一月。
10.2023年11月28日复查CT,显示最大结节0.8*0.7cm。
11.2024年9月复查,显示最大结节0.81*0.72。
12.2025年4月复查,显示最大结节0.9*0.7。 另外,看几次报告,多发磨玻璃结节数量在上升,从2022年的3个到2025年的7个。
主要询问:
1.目前复查频次是6月一次,2025年最新一次复查最大结节在增大,且多发结节数量在上升,之后是继续复查还是需要进一步治疗?如果复查的话,频次还是按6个月一次?
2.达到什么指征需要手术?如果手术的话,是需要一次把左上的两个都切了吗?
影像展示与分析:

我们发现其实各病灶与三年前比说不上显著进展。
我的意见:
两肺多发磨玻璃结节,主病灶混合密度且有小血管进入,表面不平有毛刺,考虑微浸润性腺癌或浸润性腺癌可能性大,其余部分考虑原位癌或微浸润性腺癌,部分考虑肺泡上皮增生或不典型增生可能。总体上对比2022年说不上太明显的进展。但对于是否手术来讲,我仍倾向当年的意见,左侧的可以考虑近期亚肺叶(个人倾向楔切)切除,右侧的先随访,以后有进展并风险增加再考虑干预处理。因为要拉长两次手术的间隔,这样对机体的创伤与恢复更加有利一些。若定要仍不开刀,则建议要4-6个月复查,不过个人不太主张过于保守随访,对于像主病灶这种有少许实性成分的,不能保证肯定安全。意见供参考!
感悟:
多发结节的处理到底该积极还是该保守,保守又该保守到怎样的程度?这真说不清楚。按既往经验,左上的混合密度结节应该是有一定风险的,既有毛刺,也有血管,还是偏实性成分,但它三年了,硬仍是几乎说不上明显进展。如果三年前按我的意见做了手术,是不是也是切早了呢?现在我仍建议她左侧的切了,是不是真的最合适的呢?其实我也不知道!因为我们对磨玻璃肺癌的认识仍很肤浅,对病因、发展以及如何处理仍在摸索之中。但从此例至少我们能得出的经验是:影像上考虑微浸润性腺癌且密度不太纯,或即使有微血管与毛刺征,仍不定会短期内进展。但是要说以此就得出结论以后类似影像表现的都不需要手术,仍可观察,或许也还是不一定正确的。我想医患双方仍得在不断的权衡与利弊分析当中选择自己想要的方案来随访或干预,基于当时的认知与知识面,基于当时的专家共识与指南,基于医生的临床经验与多学科讨论的结果。医生也要不断的总结反思与追求进步。

